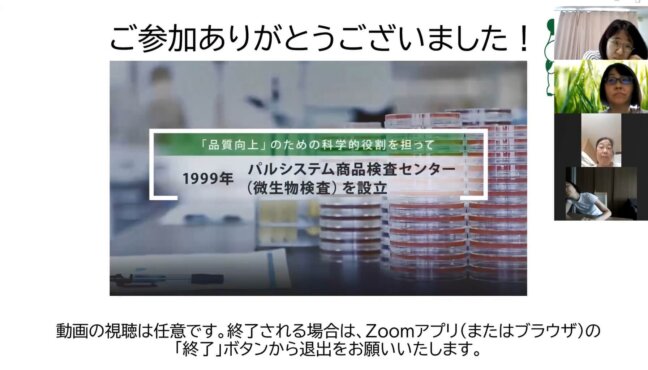

活動レポート
おうちで検査体験!商品検査センターオンライン見学会
2021.6.22

オンライン企画に参加いただいたみなさま
パルシステム商品検査センターの見学会をオンラインで開催しました!
検査室の中継や食品添加物の実験、〇✖クイズなど笑顔あふれる楽しい1時間になりました。
検査センターの紹介からはじまります!

「商品検査センターの愛称を知っていますか?」
『ぱるあんしん館』です。
20年食品の安心・安全を守ってきた施設であることがダイレクトにわかると共に、すべてひらがなにすることでお子さんにも読みやすく、また親近感を感じられるようにと、組合員への公募でつけていただきました。

検査室を見てみましょう!

まずは放射能検査室!
講師の宮本さんに検査手順や最近の検査結果の傾向などをうかがいました。
「ここ数年は、しいたけとれんこんなどの一部の根菜類など、非常に限られたものでしか検出は見られなくなってきていて、その検出値もすべてパルシステム基準より低いものになっています。」

つづいて微生物検査室!
講師の髙橋さんに検査の手順をパネルを使って、説明していただきました。
「微生物検査室では食品が衛生的かどうか?また食べても身体に影響がないかどうかを確認するために微生物の検査を行っています。」
お待たせしました!食品添加物の検査体験です!

実際に検査をやってみましょう!
パルシステムと市販のハムに亜硝酸塩が含まれているかを調べます。
ハムに水を垂らし、そこにテスターをつけます。
テスターがピンクに変わると亜硝酸塩が含まれています。

みんなで一緒にテスターをつけてみます。「せーの!!」
結果はどうでしょうか?

パルシステムのハムは白いまま。
市販のハムはピンクに変わりました!
最後に質疑応答です。

組合員のみなさんからたくさんの質問をいただき、検査センター講師がお答えしました。
企画終了後に検査センターの紹介動画を配信しました。
ご参加いただき、ありがとうございました。
当日の様子は動画(10:24)でご紹介!
ぜひ、ご覧ください!













![[食の安全学習会] 教えて!まだまだ知らないゲノム編集食品](/images/noimage.jpg)
![[食の安全学習会]種苗法改正で何が変わるの?映画「タネは誰のもの」上映会](https://www.palsystem-tokyo.coop/cms/wp-content/uploads/2021/04/28e81a04cdc224958502bd7bcd94df5b-e1757635795111.jpg)